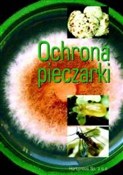
polish book : Ochrona pi... - Opracowanie Zbiorowe

Filter by price
Filter by attributes
- Availability
- hide unavailable
- Shipping
- quick dispatch
Biology and nature
|
€32.80
|
Nature's Treasures [Twarda]
|
€39.54
|
Fizjologia roślin [Miękka]
|
€17.69
|
Obserwowanie ptaków [Twarda]
|
€14.95
|
Geny [Miękka]
Zapraszamy do zakupu produktów z tej kategorii.